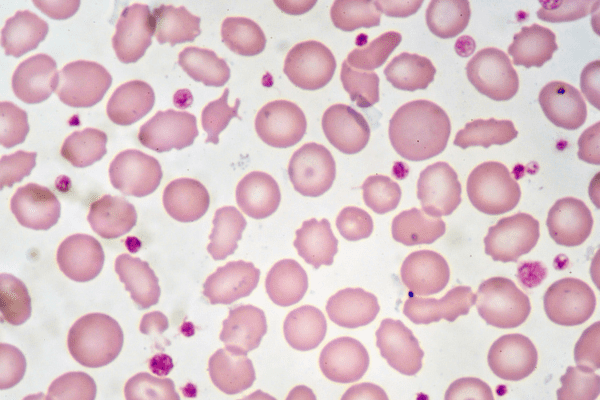
FASENRA Demonstrates Breakthrough Results in Rare Eosinophilic Disease: NATRON Trial Shows Promise for Hypereosinophilic Syndrome Patients

FASENRA Demonstrates Breakthrough Results in Rare Eosinophilic Disease: NATRON Trial Shows Promise for Hypereosinophilic Syndrome Patients
Hypereosinophilic syndrome (HES) patients may finally have a meaningful treatment option. According to an article published at BusinessWire.com, AstraZeneca's FASENRA (benralizumab) has shown statistically significant efficacy in delaying disease progression,…